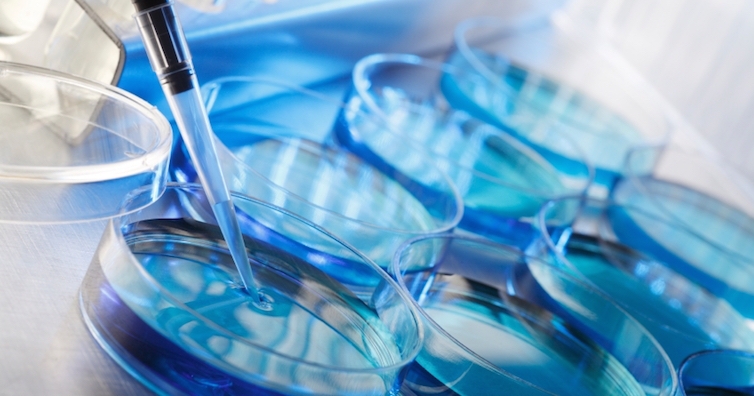

От средата на 2015 г. екипът на Медицински комплекс "Д-р Щерев" започна да работи с ново методи, които подпомагат асистираните репродуктивни технологии. Това са неинвазивни методи, благодарение на които се повишава успеваемостта при оплождане след ICSI и се постига още по-добра имплантационна успеваемост при ембриотрансфер.
В изминалия над четвърт век след първата успешна инвитро процедура в България, извършена от проф. Атанас Щерев, той и неговият екип полагат основите по модерното лечение на безплодието в България с внедряването най-иновативните методи и технологии. Тези пионерски усилия днес дават шанс за постигане на радостта от зачеването и раждането на дете дори и на безнадеждните случаи. С над 25 години успехи в асистираната репродукция екипът на Медицински комплекс „Д-р Щерев” е помогнал на хиляди български жени и двойки да изпитат най-голямата радост – звънкия смях на бебе у дома. Само за последните две години постигнатите бременности при двойки с тежък мъжки фактор е повишена с цели 15%. Репродуктивните специалисти от болницата коментираха, че причината за повишената успеваемост при инвитро е именно използването на най-новите методи като асистирания хетчинг с лазер, ембриоскопията, поляризацията на делителното вретено на яйцеклетката, IMSI, MACS, кокултивиране и други подпомагащи методики като...
Калциева активация
Това е хранителна среда, която се използва най-често при липса на оплождане, и е разработена с калциев йонофор, в която годните за инжектиране яйцеклетки се поставят след ICSI процедурата за определено време. Методиката се използва само по индикации като процедура трае средно около 2 часа. Тази среда има за цел да имитира естествената калциева активация, която настъпва след пропускането на един сперматозоид в яйцеклетката. Методът е подходящ при повторяема предходна липса на оплождане на всички яйцеклетки и последващо развитие на ембриони от тях, при получаване на ембриони с голям процент фрагментация и неправилно делене и при абнормално оплодени яйцеклетки в предходен опит.
Когато една жена има поредица от опити с нейни яйцеклетки и липса на оплождане, калциевата активация помага част от тези яйцеклетки да реализират оплождане. „Имаме активация при 75% от всички яйцеклетки, като това доведе за миналата година до 50% бременности. Новата методика значително увеличава до средно 20% шансовете при двойки, които в поредица от опити няма никакво оплождане.“, казва д-р Таня Милачич, ръководител лаборатория на ембриологичен и андрологичен сектор в Медицински комплекс „Д-р Щерев“. Техниката е позната от десетилетия в лабораторни условия, но реално в практиката при АРТ навлиза едва през последните години.
А какво се прави при повторяеми имплантационни неуспехи?
Хранителна среда при RIF/RPL
Хранителна среда, разработена с цитокини и растежни фактори, е предназначена за предимплантационни ембриони, отглеждани в инвитро условия. Използва се предимно при повторяеми имплантационни неуспехи (Reccurent implantation failure - RIF) - това представлява липса на бременност при поне 2 поредни опита с ембриони с добро качество при трансфер. Техниката се използва при поне две ранни загуби на бременност (RPL) или отчитане само на биохимична бременност (до положителен тест), при неизяснен стерилитет (при нормален яйчников отговор и нормални параметри на спермограмата). Методът увеличава средно с около 7% дела на живородените деца (от 23,1% на 29,6%), като изследването е правено при 1300 двойки в 14 инвитро центъра в Европа, което е общо с 28% повече клинични бременности.
За да предложи на своите пациенти, преминаващи през процедура по асистирана репродукция, максимална грижа от Медицински комплекс „Д-р Щерев“ инициират уникална за страната информационна програма „Какво ви предстои при инвитро“ – инициатива, която дава възможност за индивидуални информативни срещи с емоционалните консултанти на болницата, по време на които пациентите предварително да се информират за всички стъпки, през които ще преминат, за да постигнат радостта.
Каква е ролята на биолога за успеха на една ин витро процедура?
Д-р Явор Владимиров: инвитрото става все по-евтино и по-безопасно
Безплатни прегледи с ултразвуково изследване в инвитро центъра в Токуда ще се провеждат до 25 юли
Източник: 24 часа.bg

Коментари